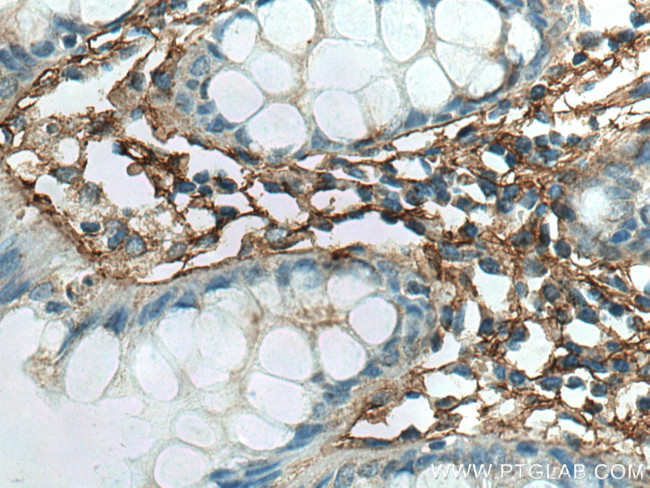
TGFBI / BIGH3 Antibody in Immunohistochemistry (Paraffin) (IHC (P))

Search
Proteintech
TGFBI / BIGH3 Monoclonal Antibody (3E11D11)
{{$productOrderCtrl.translations['antibody.pdp.commerceCard.promotion.promotions']}}
{{$productOrderCtrl.translations['antibody.pdp.commerceCard.promotion.viewpromo']}}
{{$productOrderCtrl.translations['antibody.pdp.commerceCard.promotion.promocode']}}: {{promo.promoCode}} {{promo.promoTitle}} {{promo.promoDescription}}. {{$productOrderCtrl.translations['antibody.pdp.commerceCard.promotion.learnmore']}}
产品信息
60007-1-IG
种属反应
已发表种属
宿主/亚型
分类
类型
克隆号
抗原
偶联物
形式
浓度
规格
纯化类型
保存液
内含物
保存条件
运输条件
产品详细信息
Immunogen sequence: NIQIHHYPN GIVTVNCARL LKADHHATNG VVHLIDKVIS TITNNIQQII EIEDTFETLR AAVAASGLNT MLEGNGQYTL LAPTNEAFEK IPSETLNRIL GDPEALRDLL NNHILKSAMC AEAIVAGLSV ETLEGTTLEV GCSGDMLTIN GKAIISNKDI LATNGVIHYI DELLIPDSAK TLFELAAESD VSTAIDLFRQ AGLGNHLSG (199-406 aa encoded by BC000097)
靶标信息
This gene encodes an RGD-containing protein that binds to type I, II and IV collagens. The RGD motif is found in many extracellular matrix proteins modulating cell adhesion and serves as a ligand recognition sequence for several integrins. This protein plays a role in cell-collagen interactions and may be involved in endochondrial bone formation in cartilage. The protein is induced by transforming growth factor-beta and acts to inhibit cell adhesion. Mutations in this gene are associated with multiple types of corneal dystrophy.
仅用于科研。不用于诊断过程。未经明确授权不得转售。
生物信息学
蛋白别名: Beta ig-h3; beta-ig-h3; betaig-h3; Kerato-epithelin; RGD-CAP; RGD-containing collagen-associated protein; transforming growth factor beta-induced 68kDa; transforming growth factor, beta-induced, 68kD; Transforming growth factor-beta-induced protein ig-h3; unnamed protein product
基因别名: BIGH3; CDB1; CDG2; CDGG1; CSD; CSD1; CSD2; CSD3; EBMD; LCD1; TGFBI
UniProt ID: (Human) Q15582
Entrez Gene ID: (Human) 7045